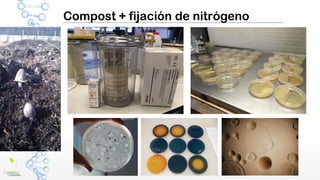
Compost + fijación de nitrógeno

El documento aborda la importancia del compostaje en la mejora de la fertilidad del suelo y la gestión de residuos orgánicos, resaltando su capacidad para mitigar el impacto ambiental y fomentar una economía circular. Se detalla el proceso de compostaje, sus beneficios, y se presentan distintas escalas y métodos de compostaje. Además, se menciona la legislación vigente sobre residuos y estándares de calidad para productos de compostaje.